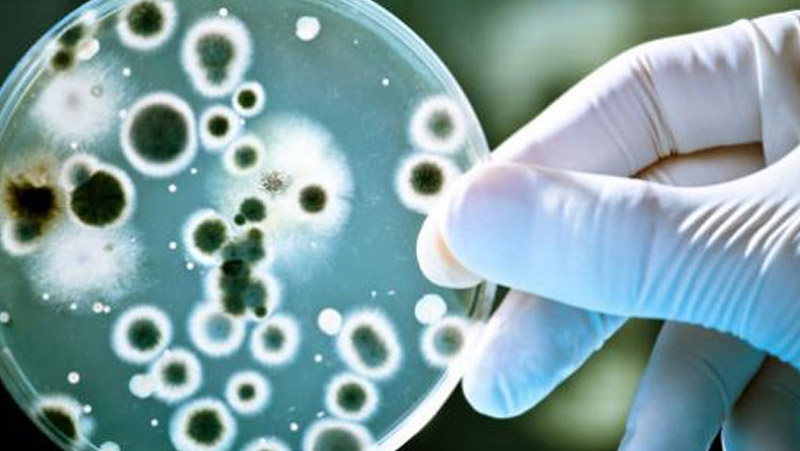

Oltre all’ipercapnia https://www.ogginotizie.info/attualita/le-persone-cominciano-a-soffrire-di-ipercapnia-il-conte-rispondera-anche-di-questo/ e tutto quello che comporta l’uso della mascherina, vi riportiamo questa testimonianza così come ce l’hanno mandata.
Tradotto da Deepl
Copialo diligentemente…!
Netfind.
Ho qualcosa da dirvi: Sono 4 settimane che ho preso il Corona. Corso moderato. Problemi di respirazione, tosse irritabile, secchezza delle mucose, mal di testa, ecc. Quindi ufficialmente si chiamerebbe così, se avessi fatto il test e fossi morto per questo, allora ovviamente sarei stato annoverato tra i morti di Corona.
Ma non ho fatto il test.
Ho visto tre medici diversi. Esame del sangue: linfociti elevati. Così l’ho diagnosticato come virale perché non c’era infiammazione.
Vai a casa e bevi molto tè e vitamina C!
Dopo 4 settimane, ancora forti dolori al petto. Nonostante gli antidepressivi (che hanno aiutato un po’) non riuscivo a superare la vita quotidiana.
Poi in una clinica di Zurigo – di cui sapevo che erano olistici. Diagnosi,
ora tieniti forte:
Infezione funginea, organi interni colpiti!
Le vie respiratorie superiori dal fungo Aspergillus e il resto Candida. Motivo della trasmissione: MASCHERA!
Sono sotto farmaci da lunedì e finalmente mi sento meglio!
Ma quello che voglio dire:
1) Avrei potuto morire, se il fungo fosse entrato nel mio sangue avrei avuto una sepsi.
2) I medici, nonostante la loro formazione e il fatto di sapere che esistono le infezioni fungine, non mi hanno nemmeno guardato a causa del panico da Corona!
3) Trovo i sintomi delle infezioni fungine interne IDENTICI a Corona, tranne la febbre.
4) Se fossi andato in ospedale, mi avrebbero rinchiuso e messo in coma.
Vi scrivo per informarvi, nel caso in cui qualcuno sia afflitto in modo simile: per favore non dimenticate i funghi.
La maschera favorisce lo sviluppo delle spore….
@peace_rocks_official